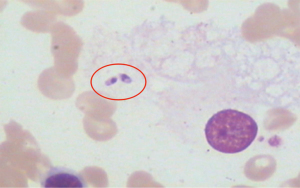

Autoimmune manifestations of visceral leishmaniasis in Chinese patients
Introduction
Visceral leishmaniasis (VL) is an infectious disease caused by the protozoan Leishmania species, mainly Leishmania donovani. It may present as an acute or chronic form and may include systemic involvement. Leishmania species are obligate intracellular parasites. They are carried in the sand fly gut as promastigotes and transmitted to humans by the bite of an infected sandfly (1,2). In tropical and subtropical countries, VL has become a major public health burden. In China, VL has been found in six provinces, including Sichuan.
VL is often asymptomatic. However, in certain situations, it may have a life-threatening course, with patients experiencing fever, weight loss, hepatosplenomegaly, and pancytopenia. Without treatment, VL can lead to a high fatality rate (2). Some laboratory features of VL, including cytopenia, hypergammaglobulinemia, and the presence of antinuclear antibodies (ANA), can resemble the laboratory features of some autoimmune diseases, especially systemic lupus erythematosus (SLE) (3-8). Although the exact immunological mechanisms related to VL is still not fully understood, the crosstalk between innate and adaptive immune systems and the type of the cell-mediated responses elicited play an important role in the disease progression (9-11). Once the infected sandflies get introduced into the skin dermis, the infective metacyclic promastigotes of Leishmania are engulfed by a variety of immune cells, such as macrophages, resident dermal dendritic cells and infiltrating neutrophils (12-14). The insertion of the sandfly’s proboscis into the skin could induce inflammation driven by neutrophils (15,16), and subsequently tissue damage. The saliva of sandfly also has chemotactic activity for neutrophils and macrophages (16,17). Degranulation of neutrophils could recruit monocytes and the release of chemokines and proinflammatory cytokines further argument this inflammation process (18-20). Final resolution of infection requires a finely tuned interaction between innate and adaptive immune systems, culminating with the activation of microbicidal and parasite clearance functions within host cells.
Although there have been some reports published on the autoimmune manifestations of VL, there is no similar report of VL in the Chinese population. Considering that there may be differences among different ethics, for the first time, we analyzed 27 Chinese patients diagnosed with VL and focused on the findings that may help clinicians to differentiate VL from SLE.
We present the following article in accordance with the STROBE reporting checklist (available at https://dx.doi.org/10.21037/apm-21-3409).
Methods
Twenty-seven consecutively hospitalized VL patients were included in this retrospective study, drawing on data from 2006 to 2019 when the patients attended Sichuan Provincial People’s Hospital. The diagnostic criteria of VL includes the detection of high titers of anti-leishmania antibodies, and these were detected by indirect immunofluorescence (IIF) assay, indirect hemagglutination antibodies, and the presence of intracellular parasites in bone marrow smears. Concretely, a confirmed case was defined with pathogenic examination (smear from bone marrow, spleen or lymph nodes to check for Leishmania spp. or culture the punctures to check for pre-flagellate Leishmania (the pre-flagellar body of Leishmania) (21). All patients were tested to ensure they were negative for hepatitis B, hepatitis C and human immunodeficiency viral infections. All procedures performed in this study involving human participants were in accordance with the Declaration of Helsinki (as revised in 2013). The study was approved by the Ethics Committee of Sichuan Provincial People’s Hospital (No. 2021-452). Individual consent for this retrospective analysis was waived.
Laboratory data were obtained by retrospective review of the patients’ charts, with all of the tests previously conducted in the Clinical Laboratory Department of Sichuan Provincial People’s Hospital. Briefly, ANA, anti-double stranded DNA (dsDNA), and anti-neutrophil cytoplasmic antibodies (ANCA) were detected using IIF (Euroimmun, Lübeck, Germany). Extractable nuclear antigen antibodies, including U1RNP antibodies, Smith antibodies (anti-Sm), anti-Sjögren’s syndrome type A antibodies (anti-SSA), anti-Sjögren’s syndrome type B antibodies (anti-SSB), liver/kidney microsomal type 1 antibodies (anti-LKM1), and anti-liver cytosol type 1 antibodies (anti-LC1) were detected using the enzyme-linked immunosorbent assay (ELISA) (Euroimmun, Lübeck, Germany). Anticardiolipin antibodies (aCL) were also detected using the ELISA (Eurimmun, German). Serum globulin levels, complement 3 protein (C3) and complement 4 protein (C4) fractions of complement and rheumatoid factor (RF) were quantitated using nephelometry (Siemens Healthcare Diagnostics, Erlangen, Germany). C-reactive protein (CRP) was examined by immunonephelometry, and values higher than 7.9 mg/L were considered positive. Serum ferritin was measured by ELISA using human anti-goat ferritin antibody (Meridian Life Science, Inc., Ohio, USA). D-dimer concentration was measured with a particle-enhanced, immunoturbidimetric assay in a calibrated SYSMEX7000 analyzer (Sysmex Corporation, Hyogo, Japan). The prothrombin time (PT) and the activated partial thromboplastin time (APTT) were also tested using the standard method.
Statistical analysis
The continuous variables were expressed as mean ± standard deviation or median (interquartile range) depending on the distribution, and the categorical data were expressed as a number (percentage). Missing data were not included for statistical analysis. Data were analyzed with SPSS v. 13.0 statistical software.
Results
Twenty-seven patients (23 men and 4 women, aged from 9 to 59 years) were included in this study (Table 1). Twenty-two of the patients were diagnosed through the identification of Leishmania amastigotes in bone marrow smear (Figure 1). One patient was diagnosed by the identification of the parasite in a bone marrow biopsy instead of a smear. Leishmania donovani was not found in either the bone marrow smears or the biopsies of the other 3 patients; however, high titers of anti-leishmania antibodies were detected in these patients, and the effective treatment response to VL confirmed the diagnosis of VL in all three of them.
Table 1
Characteristics | Patient numbers |
---|---|
Sex (female/male) | 4/23 |
Age (years), median [range] | 37 [9–59] |
Duration (months), median [range] | 1.00 [0.17–24.00] |
Anti-leishmania antibody positive, n [%] | 27 [100] |
Microscopic visualization of parasite from bone marrow aspirates or biopsy (yes/no) | 23/4 |
Fever (yes/no) | 25/2 |
Hepatosplenomegaly (yes/no) | 27/0 |
Weight loss (yes/no) | 14/13 |
VL, visceral leishmaniasis.
Routine blood and biochemical tests, immunoglobulin tests, and bone marrow examination were performed in all of the patients after hospital admission. ANA were examined in 22 patients. Laboratory tests revealed the existence of a broad spectrum of autoantibodies and hematological abnormality in VL patients (Table 2).
Table 2
Item (reference range) | Prevalence (number of patients with antibody or protein detected/total number of patients tested) | Value, mean ± SD |
---|---|---|
Anemia (<115 g/L) | 96% (26/27) | 91.7±14.7 |
Leucopenia (<3.5×109/L) | 85% (23/27) | 2.2±1.0 |
Thrombocytopenia (<101×109/L) | 74% (20/27) | 72.0±26.3 |
Extended APTT (>36.5 s) | 57% (12/21) | 39.0±8.2 |
Extended PT (>12.6 s) | 57% (12/21) | 13.2±1.9 |
Elevated D-dimer | 33% (1/5) | 19.7±38.5 |
Positive ANA | 82% (18/22) | – |
1:100 | 47.8% (11/22) | – |
1:320 | 30.4 (7/22) | – |
Anti-dsDNA | 4% (1/25) | – |
Anti-SSA | 10% (2/21) | – |
Ant-SSB | 5% (1/21) | – |
Anti-CENP-B | 19% (4/21) | – |
Anti-Jo-1 | 5% (1/21) | – |
Anti-Sm | 0 (0/21) | – |
Anti-AMA-M2 | 17% (1/6) | – |
Anti-LKM1 | 17% (1/6) | – |
Anti-LC1 | 17% (1/6) | – |
ANCA | 80% (4/5) | – |
RF (>20 IU/mL) | 27% (3/11) | 19.4±19.4 |
Direct Coombs’ test | 100 (6/6) | – |
Indirect Coombs’ test | 0 (0/6) | – |
Elevated IgG level (>16.00 g/L) | 89% (17/19) | 29.8±15.1 |
Decreased C3 level (<0.900 g/L) | 0 (0/19) | 1.2±0.3 |
Decreased C4 level (<0.100 g/L) | 0 (0/19) | 0.2±0.1 |
Elevated CRP level (>3 mg/L) | 100% (14/14) | 49.7±27.6 |
Elevated ferritin level (male >274.66 ng/mL, female >204.00 ng/mL) | 75% (6/8) | 829.3±648.5 |
SD, standard deviation; APTT, activated partial thromboplastin time; PT, prothrombin time; ANA, antinuclear antibodies; dsDNA, double-stranded DNA; SSA, Sjögren’s syndrome type A; SSB, Sjögren’s syndrome type B; CENP-B, centromere protein-B; Jo-1, histidyl-tRNA synthetase; Sm, Smith; AMA-M2, mitochondrial M2; LKM1, liver/kidney microsomal type 1; LC1, liver cytosol specific type 1; ANCA, anti-neutrophil cytoplasmic antibodies; RF, rheumatoid factor; IgG, immunoglobulin G; C3, complement 3 protein; C4, complement 4 protein; CRP, C-reactive protein.
All patients were cured after treatment with sodium antimony gluconate. One patient was followed up and re-evaluated 1 month after therapy. Before treatment, the patient’s ANA titer was 1:320, and the patient tested positive for many autoimmune antibodies, including anti-dsDNA, anti-histone antibody, anti-Jo-1 antibody, and P-ANCA. Serum levels of CRP, ferritin and IgG were elevated to 48.8 mg/L, 1,556.82 ng/mL, and 22 g/L, respectively. One month after treatment, the patient’s ANA titer remained positive (1:320), while all the other autoimmune antibodies returned a negative result on testing. Serum levels of CRP, ferritin, and IgG returned to normal.
Discussion
The hallmarks of VL may mimic symptoms of autoimmune diseases, especially of SLE. The presenting autoimmune symptoms of VL patients generally include pancytopenia, hypergammaglobulinemia, and the production of autoantibodies, such as ANA, and others. Polyclonal activation of B cells is considered to be the main reason of immunoglobulin and autoantibody formation (22,23). Extensive cross-linking of membrane immunoglobulins by microbial antigens or cytokines produced by other cells can stimulate the polyclonal activation of B cells (24). In addition, Leishmania parasites, themselves, may cause tissue destruction, thus releasing self-antigens, which act as B-cell mitogens (23).
Some small case series have reported the presence of immunocomplexes, complement consumption, and elevated antibodies in VL patients (5,24,25). Most of these studies have involved Caucasian patients, and there has been scant research of VL in Asian patients. Out study is the first known study to report the autoimmune manifestations of VL patients in China. Since several factors relating to hosts, vectors, and parasites have been implicated as determinants of VL (26), there may be some differences in the autoimmune manifestations between Chinese VL patients and VL patients from other continents.
In clinical practice, VL patients often present with increased levels of serum immunoglobulins and increased production of autoantibodies, which could easily lead to a misdiagnosis as SLE. Recently, Santana et al. reviewed original studies of cases of VL-infected patients, in order to identify the clinical and laboratory manifestations of VL mimicking SLE (7). The literature review identified 18 cases of VL mimicking SLE. The most common manifestations in VL patients were reported as intermittent fever, pancytopenia, visceromegaly, and increased acute phase reactants. The most common laboratory results were positive ANA (17 cases, 94%), positive RF (10 cases, 56%), and positive direct Coombs’ (9 cases, 50%) tests. Even for tests generally considered highly specific for SLE, such as the anti-dsDNA test, the prevalence of a positive result in VL patients was 16% (25,27). Other autoimmune antibodies, such as RF, an-dsDNA, anti-Sm and ANCA, were detected in 24.4–63%, 4.5%, 6%, and 25% of VL patients, respectively. The results of direct and indirect Coombs’ tests were positive in 13% and 6% of VL patients, respectively, and some studies showed decreased C3 and C4 levels in VL patients (25). In this current study, all the patients had cytopenia (82% with pancytopenia) and hepatosplenomegaly, and most of them (93%) presented with fever. In the patients who underwent laboratory tests, increased serum levels of CRP, IgG, and ANA were generally noted. This was consistent with most results previously reported. Of note, the prevalence of ANCA (80%) and the prevalence of direct Coombs’ (100%) in this current study were higher than those of other studies; although in this study, these were not tested in every patient. The prevalence of anti-dsDNA was low (5%) in this study, and another highly specific antibody of SLE, anti-Sm, was absent. Levels of C3 and C4, APTT, and PT were normal in VL patients. APTT and PT are typically normal in VL patients, and the same was observed in the current study.
In this study, clinical and laboratory manifestations mimicking SLE in Chinese VL patients were identified, as has been reported in other countries. The prevalence of autoantibodies and other laboratory parameters differed significantly from other studies, which should prompt further investigation to explore the genetic and racial characteristics of VL as well as the differences between the leishmaniasis strains.
VL commonly resembles SLE, yet the distinction between the two illnesses is sometimes difficult to tell. Here, the clinical and laboratory findings of VL are presented which may help medical practitioners to differentiate these two entities. The hematological abnormalities of SLE include hemolytic anemia, leucopenia or lymphopenia, and thrombocytopenia, due to the presence of autoantibodies directed against erythrocytes, leucocytes, and platelets (28). Splenomegaly is not commonly seen in SLE patients, unless lymphoma or other concurrent infection is combined. However, splenomegaly is quite common in VL, due to the proliferation of parasites, and so cytopenia in VL patients is mainly due to splenomegaly and hypersplenism. In addition, the highly elevated CRP commonly seen in VL is not usually seen in SLE, unless symmetrical polyarthritis, pleurisy, or concurrent infection occurs. Hypergammaglobulinemia, while common in SLE patients, is much more common in VL patients. In this study, the IgG level of one VL patient was 61 g/L. However, in SLE patients, highly elevated IgG is rare. Furthermore, the failure of steroid treatment and the normal levels of C3 and C4 suggested a possible infectious origin. In this study, VL was more prevalent in male patients; SLE, in contrast, tends to be more prevalent in females. However, considering the relatively small number of patients in this study, further studies with an expanded sample size are needed to confirm the real incidence of VL among specific populations.
On the other hand, underlying factors, such as malnutrition, HIV coinfection, or treatment with corticosteroids or immunosuppressive drugs are contributory factors in disease reactivation, hence VL may also occur in SLE patients as an opportunistic infection and mimic SLE flare-up, as previously reported (29). Therefore, VL must be ruled out diligently before starting immunosuppressive therapy in patients with immunological abnormalities, especially in endemic areas. Moreover, VL should be considered in patients with autoimmune disorders who do not respond to steroid and immunosuppressive treatment. For those suspected cases in high-risk endemic areas, high titers of anti-leishmania antibodies are helpful for VL diagnosis, but it does not serve as the unique diagnostic criterion owing to diversified test methods and lack of uniform standards. Once diagnosed, specific treatment should be initiated. Antimonials are considered as the most effective choice for VL, and Liposomal amphotericin B is also thought to be an effective and safe choice in most cases. In our study, all patients were cured after treatment with antimonials.
It has to be noted that the sample sizes included in all the current studies exploring the autoimmune features of VL are relatively small, which may due to the relatively low incidence of VL and low detection of autoimmune abnormalities. However, if the autoimmune features of VL are ignored, it is an easily misdiagnosed disease. More studies with larger samples need to be conducted in the future for better illustration of the problem.
Acknowledgments
Funding: The research was supported by the Foundation of Outstanding Young Talents, Science and Technology Department of Sichuan Province (2020JDJQ0067).
Footnote
Reporting Checklist: The authors have completed the STROBE reporting checklist. Available at https://dx.doi.org/10.21037/apm-21-3409
Data Sharing Statement: Available at https://dx.doi.org/10.21037/apm-21-3409
Conflicts of Interest: All authors have completed the ICMJE uniform disclosure form (available at https://dx.doi.org/10.21037/apm-21-3409). The authors report that this research was funded by the Foundation for Outstanding Young Talents, Science and Technology Department of Sichuan Province (2020JDJQ0067). The authors have no other conflicts of interest to declare.
Ethical Statement: The authors are accountable for all aspects of the work in ensuring that questions related to the accuracy or integrity of any part of the work are appropriately investigated and resolved. All procedures performed in this study involving human participants were in accordance with the Declaration of Helsinki (as revised in 2013). The study was approved by the Ethics Committee of Sichuan Provincial People’s Hospital (No. 2021-452). Individual consent for this retrospective analysis was waived.
Open Access Statement: This is an Open Access article distributed in accordance with the Creative Commons Attribution-NonCommercial-NoDerivs 4.0 International License (CC BY-NC-ND 4.0), which permits the non-commercial replication and distribution of the article with the strict proviso that no changes or edits are made and the original work is properly cited (including links to both the formal publication through the relevant DOI and the license). See: https://creativecommons.org/licenses/by-nc-nd/4.0/.
References
- Burza S, Croft SL, Boelaert M. Leishmaniasis. Lancet 2018;392:951-70. [Crossref] [PubMed]
- Pérez-Ayala A, Norman F, Pérez-Molina JA, et al. Imported leishmaniasis: a heterogeneous group of diseases. J Travel Med 2009;16:395-401. [Crossref] [PubMed]
- Bueno GCL, Koerich ATS, Burg LB, et al. Visceral leishmaniasis mimicking systemic lupus erythematosus. Rev Soc Bras Med Trop 2019;52:e20180208. [Crossref] [PubMed]
- Tunccan OG, Tufan A, Telli G, et al. Visceral leishmaniasis mimicking autoimmune hepatitis, primary biliary cirrhosis, and systemic lupus erythematosus overlap. Korean J Parasitol 2012;50:133-6. [Crossref] [PubMed]
- Arlet JB, Capron L, Pouchot J. Visceral leishmaniasis mimicking systemic lupus erythematosus. J Clin Rheumatol 2010;16:203-4. [Crossref] [PubMed]
- Voulgarelis M, Voulgari PV, Serelis J, et al. Visceral leishmaniasis resembling systemic lupus erythematosus. Clin Rheumatol 2003;22:452-5. [Crossref] [PubMed]
- Santana IU, Dias B, Nunes EA, et al. Visceral leishmaniasis mimicking systemic lupus erythematosus: Case series and a systematic literature review. Semin Arthritis Rheum 2015;44:658-65. [Crossref] [PubMed]
- Sakkas LI, Boulbou M, Kyriakou D, et al. Immunological features of visceral leishmaniasis may mimic systemic lupus erythematosus. Clin Biochem 2008;41:65-8. [Crossref] [PubMed]
- Kaye PM. The Immunology of Visceral Leishmaniasis: Current Status. In: Farrell JP, editor. Leishmania. Boston, MA: Springer US, 2002:137-50.
- Hohman LS, Peters NC. CD4+ T Cell-Mediated Immunity against the Phagosomal Pathogen Leishmania: Implications for Vaccination. Trends Parasitol 2019;35:423-35. [Crossref] [PubMed]
- Kaye P, Scott P. Leishmaniasis: complexity at the host-pathogen interface. Nat Rev Microbiol 2011;9:604-15. [Crossref] [PubMed]
- Gonçalves-de-Albuquerque SDC, Pessoa-E-Silva R, Trajano-Silva LAM, et al. The Equivocal Role of Th17 Cells and Neutrophils on Immunopathogenesis of Leishmaniasis. Front Immunol 2017;8:1437. [Crossref] [PubMed]
- Peters NC, Egen JG, Secundino N, et al. In vivo imaging reveals an essential role for neutrophils in leishmaniasis transmitted by sand flies. Science 2008;321:970-4. [Crossref] [PubMed]
- Gorak PM, Engwerda CR, Kaye PM. Dendritic cells, but not macrophages, produce IL-12 immediately following Leishmania donovani infection. Eur J Immunol 1998;28:687-95. [Crossref] [PubMed]
- Carneiro MB, Hohman LS, Egen JG, et al. Use of two-photon microscopy to study Leishmania major infection of the skin. Methods 2017;127:45-52. [Crossref] [PubMed]
- Lestinova T, Rohousova I, Sima M, et al. Insights into the sand fly saliva: Blood-feeding and immune interactions between sand flies, hosts, and Leishmania. PLoS Negl Trop Dis 2017;11:e0005600. [Crossref] [PubMed]
- Abdeladhim M, Kamhawi S, Valenzuela JG. What's behind a sand fly bite? The profound effect of sand fly saliva on host hemostasis, inflammation and immunity. Infect Genet Evol 2014;28:691-703. [Crossref] [PubMed]
- Mantovani A, Cassatella MA, Costantini C, et al. Neutrophils in the activation and regulation of innate and adaptive immunity. Nat Rev Immunol 2011;11:519-31. [Crossref] [PubMed]
- Brinkmann V, Zychlinsky A. Beneficial suicide: why neutrophils die to make NETs. Nat Rev Microbiol 2007;5:577-82. [Crossref] [PubMed]
- Charmoy M, Brunner-Agten S, Aebischer D, et al. Neutrophil-derived CCL3 is essential for the rapid recruitment of dendritic cells to the site of Leishmania major inoculation in resistant mice. PLoS Pathog 2010;6:e1000755. [Crossref] [PubMed]
- Jun-Yun W, Chun-Hua G. Interpretation of Diagnostic Criteria for Kala-azar. Zhongguo Xue Xi Chong Bing Fang Zhi Za Zhi 2017;29:541-3. [PubMed]
- Galvão-Castro B, Sá Ferreira JA, Marzochi KF, et al. Polyclonal B cell activation, circulating immune complexes and autoimmunity in human american visceral leishmaniasis. Clin Exp Immunol 1984;56:58-66. [PubMed]
- Smelt SC, Cotterell SE, Engwerda CR, et al. B cell-deficient mice are highly resistant to Leishmania donovani infection, but develop neutrophil-mediated tissue pathology. J Immunol 2000;164:3681-8. [Crossref] [PubMed]
- Deak E, Jayakumar A, Cho KW, et al. Murine visceral leishmaniasis: IgM and polyclonal B-cell activation lead to disease exacerbation. Eur J Immunol 2010;40:1355-68. [Crossref] [PubMed]
- Argov S, Jaffe CL, Krupp M, et al. Autoantibody production by patients infected with Leishmania. Clin Exp Immunol 1989;76:190-7. [PubMed]
- Liberopoulos E, Kei A, Apostolou F, et al. Autoimmune manifestations in patients with visceral leishmaniasis. J Microbiol Immunol Infect 2013;46:302-5. [Crossref] [PubMed]
- McCall LI, Zhang WW, Matlashewski G. Determinants for the development of visceral leishmaniasis disease. PLoS Pathog 2013;9:e1003053. [Crossref] [PubMed]
- Mohan C, Adams S, Stanik V, et al. Nucleosome: a major immunogen for pathogenic autoantibody-inducing T cells of lupus. J Exp Med 1993;177:1367-81. [Crossref] [PubMed]
- Braun J, Sieper J, Schulte KL, et al. Visceral leishmaniasis mimicking a flare of systemic lupus erythematosus. Clin Rheumatol 1991;10:445-8. [Crossref] [PubMed]
(English Language Editor: K. Gilbert)